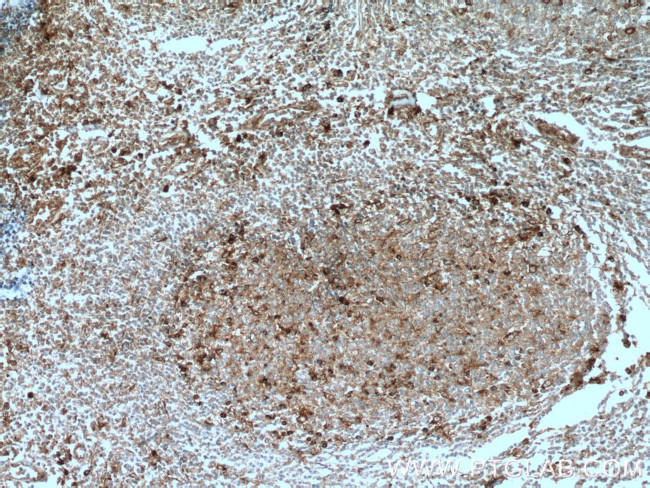
SELPLG Antibody in Immunohistochemistry (Paraffin) (IHC (P))

Search
Proteintech
SELPLG Polyclonal Antibody
{{$productOrderCtrl.translations['antibody.pdp.commerceCard.promotion.promotions']}}
{{$productOrderCtrl.translations['antibody.pdp.commerceCard.promotion.viewpromo']}}
{{$productOrderCtrl.translations['antibody.pdp.commerceCard.promotion.promocode']}}: {{promo.promoCode}} {{promo.promoTitle}} {{promo.promoDescription}}. {{$productOrderCtrl.translations['antibody.pdp.commerceCard.promotion.learnmore']}}
产品信息
23605-1-AP
种属反应
已发表种属
宿主/亚型
分类
类型
抗原
偶联物
形式
浓度
规格
纯化类型
保存液
内含物
保存条件
运输条件
产品详细信息
Immunogen sequence: TTQPAATEA QTTPLAATEA QTTRLTATEA QTTPLAATEA QTTPPAATEA QTTQPTGLEA QTTAPAAMEA QTTAPAAMEA QTTPPAAMEA QTTQTTAMEA QTTAPEATEA QTTQPTATEA QTTPLAAMEA LSTEPSATEA LSMEPTTKRG LFIPFSVSSV THKGIPMAAS NLSVNYPVGA PDHISVKQCL LAILILALVA TIFFVCTVVL AVRLSRKGHM YPVRNYSPTE MVCISSLLPD GGEGPSATAN GGLSKAKSPG LTPEPREDRE GDDLTLHSFL P (133-412 aa encoded by BC029782)
靶标信息
CD162 (PSGL-1) is a 120 kDa homodimer protein found on the surface of leukocytes and platelets. CD162 is known to bind CD62P (P-selectin), CD62L (L-selectin), and to a lower degree CD62E (E-selectin). These interactions play a critical role in leukocyte adhesion, rolling and extravasation. CD162 has been shown to be an important immune marker of T cell exhaustion in chronic viral infections and cancer.
仅用于科研。不用于诊断过程。未经明确授权不得转售。
生物信息学
蛋白别名: CD162; Cutaneous lymphocyte associated antigen; cutaneous lymphocyte-associated associated antigen; P-selectin glycoprotein ligand 1; PSGL-1; Selectin P ligand; SELPG; unnamed protein product
基因别名: CD162; CLA; PSGL-1; PSGL1; SELPLG
UniProt ID: (Human) Q14242
Entrez Gene ID: (Human) 6404